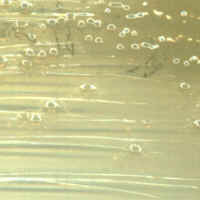

Tour of Microbes Tour Home | Disease Home | Microbes A to Z | Bio 203 Home |
Proteus are Gram-negative rod-shaped Enterobacteria common to soils and the digestive tracts of animals. Most strains are motile by peritrichous flagella and exhibit swarming behavior on agar plates.
Proteobacteria (Volume 2)
Facultative anaerobe, oxidase-negative, catalase-positive, nitrate reduction-positive
Metabolism: respiratory and fermentative,
Hydrolysis: amylase-negative, casease-negative, DNAse-negative, gelatinase-positive
Other: H2S-positive, indole-negative, citrate-positive, urease-positive
Structure: motile